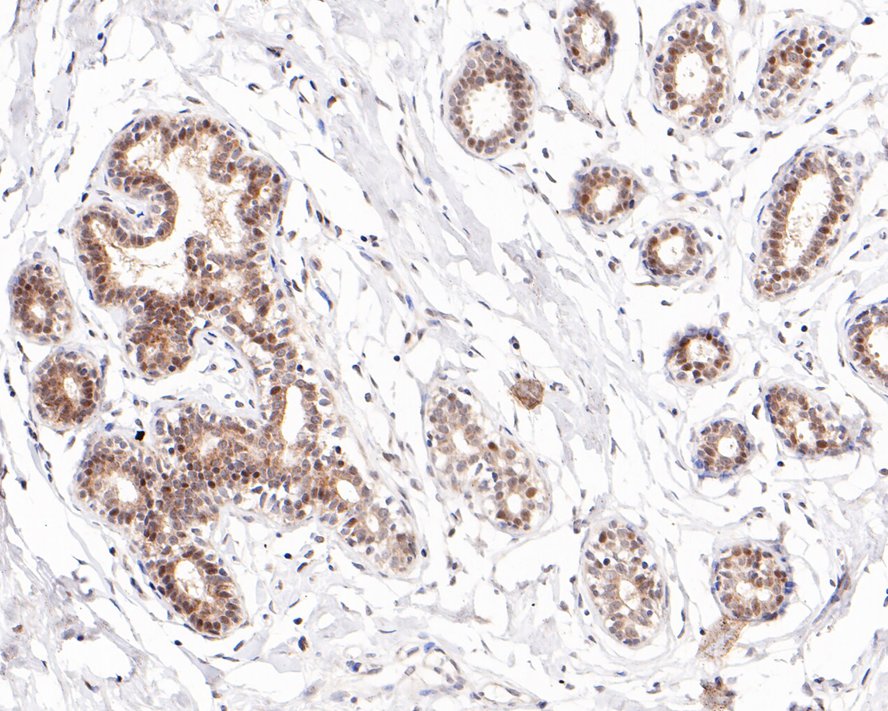

Catalog# 0803-1
ESR1 Rabbit Polyclonal Antibody
Application
-
WB
-
IF-Cell
-
IHC-P
Reactivity
-
Human